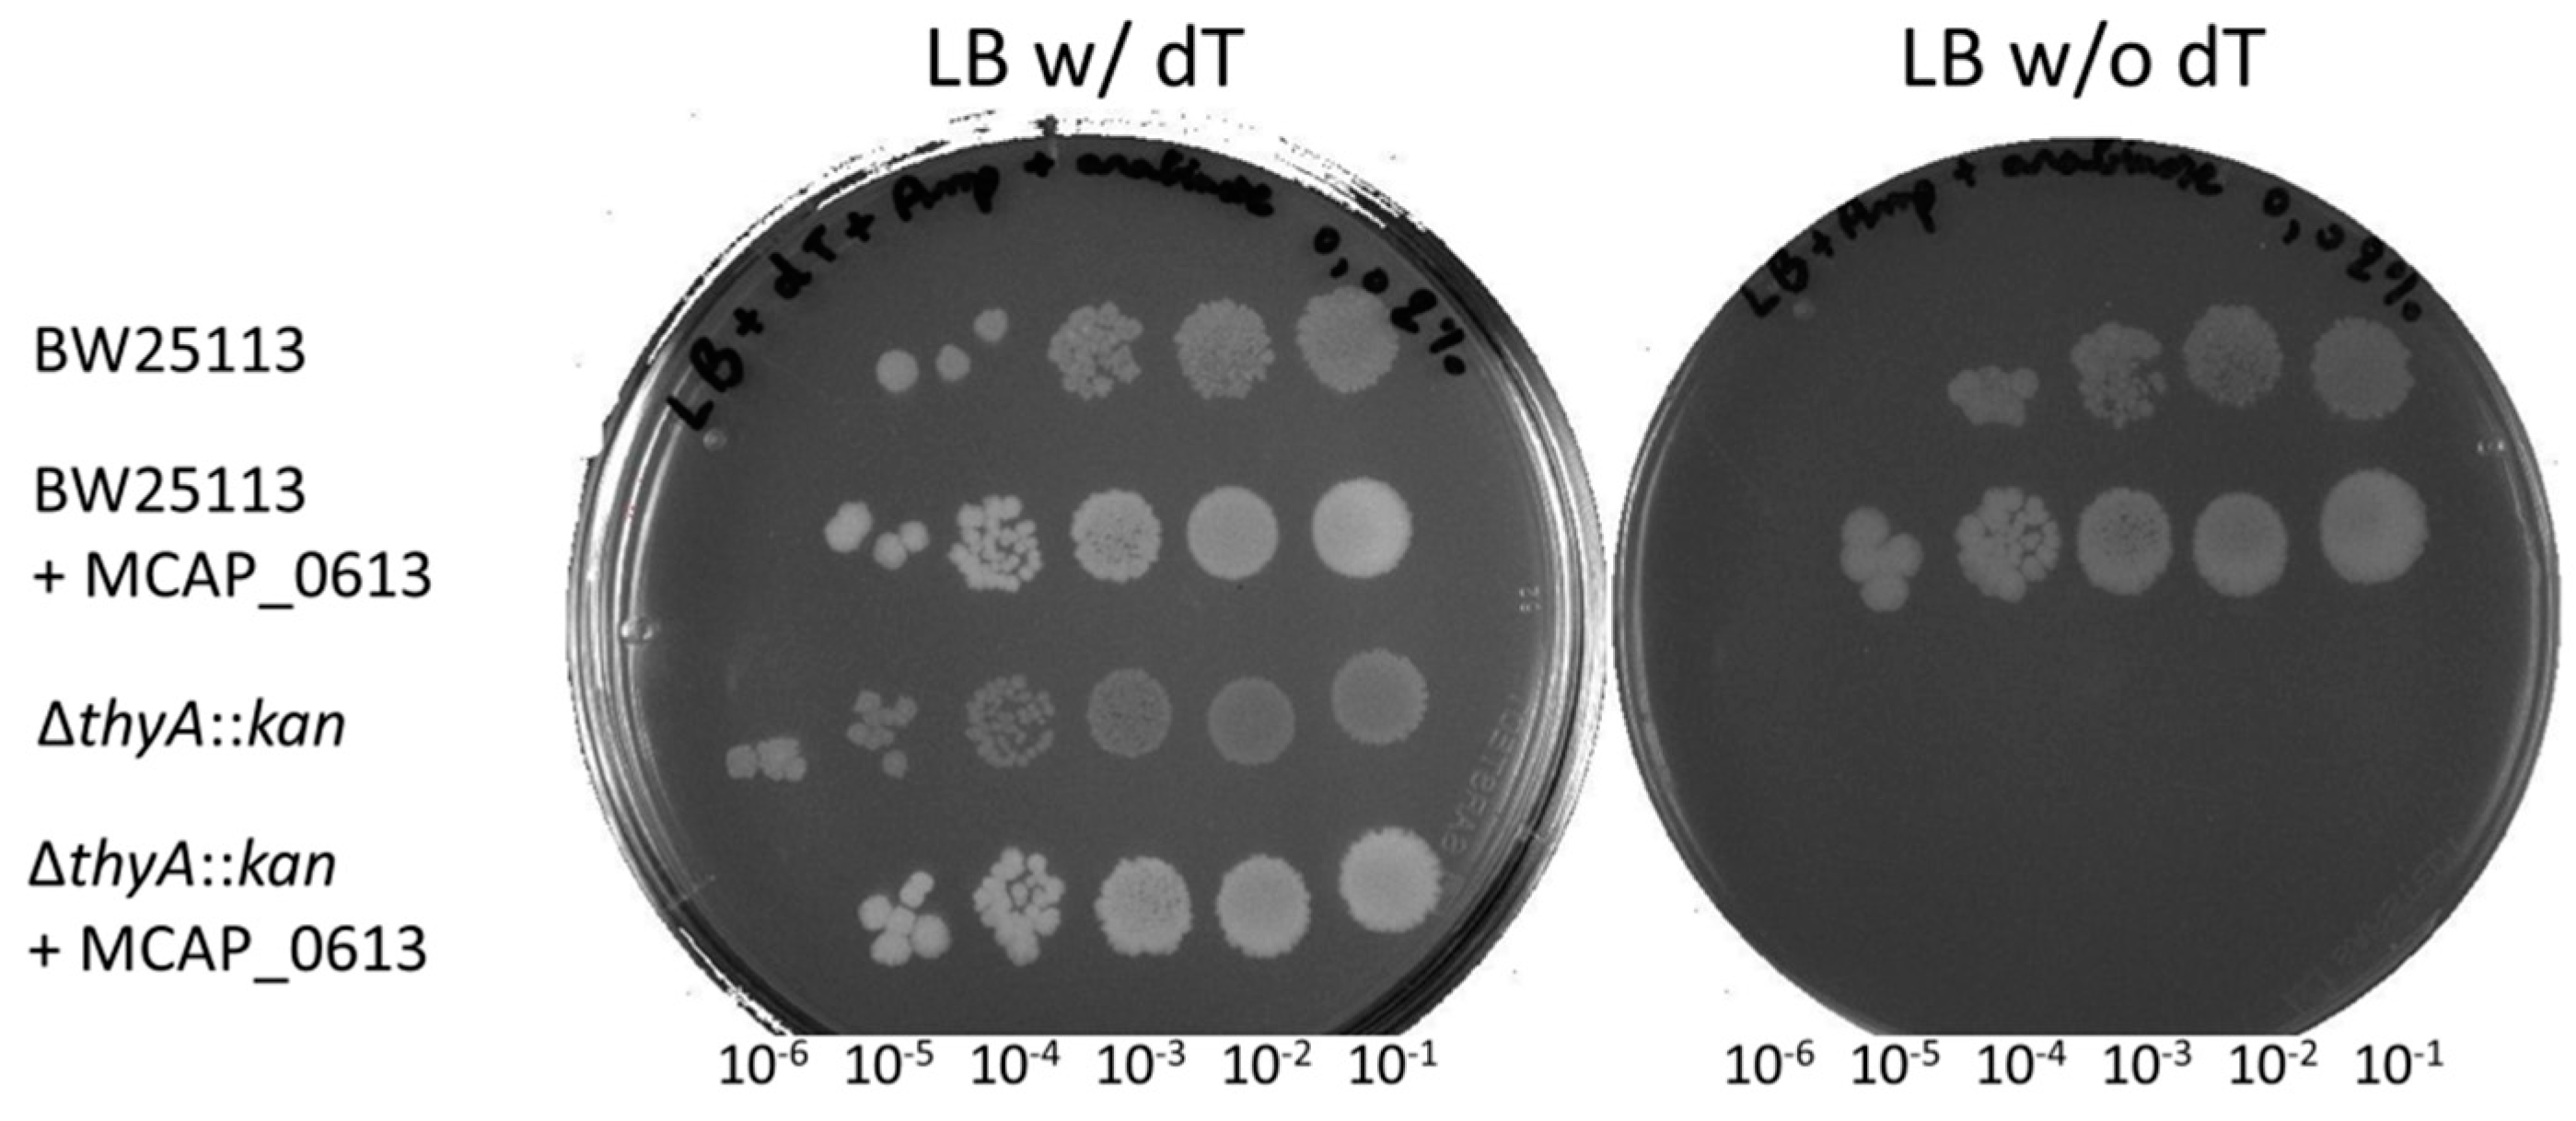
Biomolecules 10 00587 g007

Reductive Evolution and Diversification of C5-Uracil Methylation in the Nucleic Acids of Mollicutes
Abstract
1. Introduction
2. Materials and Methods
2.1. In silico Genome and Protein Analyses
2.2. Functional Domain Analysis and Secondary Structure Prediction
2.3. RNA Extraction and HPLC Analysis of tRNAs
2.4. Analysis of RNA by Matrix-Assisted Laser Desorption/Ionization Mass Spectrometry (MALDI-MS)
2.5. Complementation Tests of ∆thyA::kan E. coli Strain
3. Results
3.1. Distribution of Predicted 5-Methyluracil Synthesis Enzymes in Mollicutes
3.2. Synthesis by ThyA Homologs and deoxyT Salvage are the Two Main Routes to dTMP Synthesis in Mollicutes
3.3. Most Mollicutes Have Lost the m5U54 Modification in tRNA
3.4. Mollicutes Modify 23S rRNA m5U1939 via either RlmD or RlmFO
3.5. Binding Sites of Folate and Flavin are Conserved in TrmFO-like Proteins
3.6. Modeling of TrmFO-Like Protein Structures Indicates Diverse Functions
4. Discussion
5. Conclusions
Supplementary Materials
Author Contributions
Funding
Acknowledgments
Conflicts of Interest
References
- Hori, H. Methylated nucleosides in tRNA and tRNA methyltransferases. Front. Genet. 2014, 5, 144. [Google Scholar] [CrossRef] [PubMed]
- Motorin, Y.; Helm, M. RNA nucleotide methylation. Wiley Interdiscip. Rev. RNA 2011, 2, 611–631. [Google Scholar] [CrossRef] [PubMed]
- Myllykallio, H.; Sournia, P.; Heliou, A.; Liebl, U. Unique features and anti-microbial targeting of folate- and flavin-dependent methyltransferases required for accurate maintenance of genetic information. Front. Microbiol. 2018, 9, 918. [Google Scholar] [CrossRef]
- Juhling, F.; Morl, M.; Hartmann, R.K.; Sprinzl, M.; Stadler, P.F.; Putz, J. tRNAdb 2009: Compilation of tRNA sequences and tRNA genes. Nucleic Acids Res. 2009, 37, D159–D162. [Google Scholar] [CrossRef] [PubMed]
- Felden, B.; Hanawa, K.; Atkins, J.F.; Himeno, H.; Muto, A.; Gesteland, R.F.; McCloskey, J.A.; Crain, P.F. Presence and location of modified nucleotides in Escherichia coli tmRNA: Structural mimicry with tRNA acceptor branches. EMBO J. 1998, 17, 3188–3196. [Google Scholar] [CrossRef]
- Boccaletto, P.; Machnicka, M.A.; Purta, E.; Piatkowski, P.; Baginski, B.; Wirecki, T.K.; de Crécy-Lagard, V.; Ross, R.; Limbach, P.A.; Kotter, A.; et al. MODOMICS: A database of RNA modification pathways. 2017 update. Nucleic Acids Res. 2018, 46, D303–D307. [Google Scholar] [CrossRef]
- Johnson, L.; Hayashi, H.; Söll, D. Isolation and properties of a transfer ribonucleic acid deficient in ribothymidine. Biochemistry 1970, 9, 2823–2831. [Google Scholar] [CrossRef]
- Vani, B.R.; Ramakrishnan, T.; Taya, Y.; Noguchi, S.; Yamaizumi, Z.; Nishimura, S. Occurrence of 1-methyladenosine and absence of ribothymidine in transfer ribonucleic acid of Mycobacterium smegmatis. J. Bacteriol. 1979, 137, 1084–1087. [Google Scholar] [CrossRef]
- Hsuchen, C.C.; Dubin, D.T. Methylation patterns of mycoplasma transfer and ribosomal ribonucleic acid. J. Bacteriol. 1980, 144, 991–998. [Google Scholar] [CrossRef]
- Piekna-Przybylska, D.; Decatur, W.A.; Fournier, M.J. The 3D rRNA modification maps database: With interactive tools for ribosome analysis. Nucleic Acids Res. 2008, 36, D178–D183. [Google Scholar] [CrossRef]
- Sergeeva, O.V.; Bogdanov, A.A.; Sergiev, P.V. What do we know about ribosomal RNA methylation in Escherichia coli? Biochimie 2015, 117, 110–118. [Google Scholar] [CrossRef] [PubMed]
- Motorin, Y.; Helm, M. tRNA stabilization by modified nucleotides. Biochemistry 2010, 49, 4934–4944. [Google Scholar] [CrossRef]
- Chawla, M.; Oliva, R.; Bujnicki, J.M.; Cavallo, L. An atlas of RNA base pairs involving modified nucleobases with optimal geometries and accurate energies. Nucleic Acids Res. 2015, 43, 6714–6729. [Google Scholar] [CrossRef]
- Lorenz, C.; Lunse, C.E.; Morl, M. tRNA modifications: Impact on structure and thermal adaptation. Biomolecules 2017, 7, 35. [Google Scholar] [CrossRef] [PubMed]
- Whipple, J.M.; Lane, E.A.; Chernyakov, I.; D’Silva, S.; Phizicky, E.M. The yeast rapid tRNA decay pathway primarily monitors the structural integrity of the acceptor and T-stems of mature tRNA. Genes Dev. 2011, 25, 1173–1184. [Google Scholar] [CrossRef]
- Hopper, A.K.; Huang, H.Y. Quality control pathways for nucleus-encoded eukaryotic tRNA biosynthesis and subcellular trafficking. Mol. Cell. Biol. 2015, 35, 2052–2058. [Google Scholar] [CrossRef]
- Chen, W.; Li, Y.; Li, J.; Wu, L.; Wang, R.; Deng, Z.; Zhou, J. An unusual UMP C-5 methylase in nucleoside antibiotic polyoxin biosynthesis. Protein Cell 2016, 7, 673–683. [Google Scholar] [CrossRef] [PubMed]
- Hamdane, D.; Grosjean, H.; Fontecave, M. Flavin-dependent methylation of RNAs: Complex chemistry for a simple modification. J. Mol. Biol. 2016, 428, 4867–4881. [Google Scholar] [CrossRef]
- Hou, Y.M.; Perona, J.J. Stereochemical mechanisms of tRNA methyltransferases. FEBS Lett. 2010, 584, 278–286. [Google Scholar] [CrossRef]
- Kealey, J.T.; Gu, X.; Santi, D.V. Enzymatic mechanism of tRNA (m5U54)methyltransferase. Biochimie 1994, 76, 1133–1142. [Google Scholar] [CrossRef]
- Swinehart, W.E.; Jackman, J.E. Diversity in mechanism and function of tRNA methyltransferases. RNA Biol. 2015, 12, 398–411. [Google Scholar] [CrossRef]
- Carreras, C.W.; Santi, D.V. The catalytic mechanism and structure of thymidylate synthase. Annu. Rev. Biochem. 1995, 64, 721–762. [Google Scholar] [CrossRef] [PubMed]
- Myllykallio, H.; Leduc, D.; Filee, J.; Liebl, U. Life without dihydrofolate reductase FolA. Trends Microbiol. 2003, 11, 220–223. [Google Scholar] [CrossRef]
- Myllykallio, H.; Lipowski, G.; Leduc, D.; Filee, J.; Forterre, P.; Liebl, U. An alternative flavin-dependent mechanism for thymidylate synthesis. Science 2002, 297, 105–107. [Google Scholar] [CrossRef]
- Mishanina, T.V.; Yu, L.; Karunaratne, K.; Mondal, D.; Corcoran, J.M.; Choi, M.A.; Kohen, A. An unprecedented mechanism of nucleotide methylation in organisms containing thyX. Science 2016, 351, 507–510. [Google Scholar] [CrossRef] [PubMed]
- Bou-Nader, C.; Cornu, D.; Guerineau, V.; Fogeron, T.; Fontecave, M.; Hamdane, D. Enzyme activation with a synthetic catalytic co-enzyme intermediate: Nucleotide methylation by flavoenzymes. Angew. Chem. Int. Ed. Engl. 2017, 56, 12523–12527. [Google Scholar] [CrossRef] [PubMed]
- Conrad, J.A.; Ortiz-Maldonado, M.; Hoppe, S.W.; Palfey, B.A. Detection of intermediates in the oxidative half-reaction of the FAD-dependent thymidylate synthase from Thermotoga maritima: Carbon transfer without covalent pyrimidine activation. Biochemistry 2014, 53, 5199–5207. [Google Scholar] [CrossRef]
- Delk, A.S.; Nagle, D.P., Jr.; Rabinowitz, J.C. Methylenetetrahydrofolate-dependent biosynthesis of ribothymidine in transfer RNA of Streptococcus faecalis. Evidence for reduction of the 1-carbon unit by FADH2. J. Biol. Chem. 1980, 255, 4387–4390. [Google Scholar]
- Nishimasu, H.; Ishitani, R.; Yamashita, K.; Iwashita, C.; Hirata, A.; Hori, H.; Nureki, O. Atomic structure of a folate/FAD-dependent tRNA T54 methyltransferase. Proc. Natl. Acad. Sci. USA 2009, 106, 8180–8185. [Google Scholar] [CrossRef]
- Urbonavicius, J.; Skouloubris, S.; Myllykallio, H.; Grosjean, H. Identification of a novel gene encoding a flavin-dependent tRNA:m5U methyltransferase in bacteria--evolutionary implications. Nucleic Acids Res. 2005, 33, 3955–3964. [Google Scholar] [CrossRef]
- Björk, G.R. Transductional mapping of gene trmA responsible for the production of 5-methyluridine in transfer ribonucleic acid of Escherichia coli. J. Bacteriol. 1975, 124, 92–98. [Google Scholar] [CrossRef] [PubMed]
- Ny, T.; Bjork, G.R. Cloning and restriction mapping of the trmA gene coding for transfer ribonucleic acid (5-methyluridine)-methyltransferase in Escherichia coli K-12. J. Bacteriol. 1980, 142, 371–379. [Google Scholar] [CrossRef] [PubMed]
- Ranaei-Siadat, E.; Fabret, C.; Seijo, B.; Dardel, F.; Grosjean, H.; Nonin-Lecomte, S. RNA-methyltransferase TrmA is a dual-specific enzyme responsible for C5-methylation of uridine in both tmRNA and tRNA. RNA Biol. 2013, 10, 572–578. [Google Scholar] [CrossRef] [PubMed]
- Agarwalla, S.; Kealey, J.T.; Santi, D.V.; Stroud, R.M. Characterization of the 23 S ribosomal RNA m5U1939 methyltransferase from Escherichia coli. J. Biol. Chem. 2002, 277, 8835–8840. [Google Scholar] [CrossRef]
- Madsen, C.T.; Mengel-Jorgensen, J.; Kirpekar, F.; Douthwaite, S. Identifying the methyltransferases for m(5)U747 and m(5)U1939 in 23S rRNA using MALDI mass spectrometry. Nucleic Acids Res. 2003, 31, 4738–4746. [Google Scholar] [CrossRef][Green Version]
- Desmolaize, B.; Fabret, C.; Bregeon, D.; Rose, S.; Grosjean, H.; Douthwaite, S. A single methyltransferase YefA (RlmCD) catalyses both m5U747 and m5U1939 modifications in Bacillus subtilis 23S rRNA. Nucleic Acids Res. 2011, 39, 9368–9375. [Google Scholar] [CrossRef]
- Lartigue, C.; Lebaudy, A.; Blanchard, A.; El Yacoubi, B.; Rose, S.; Grosjean, H.; Douthwaite, S. The flavoprotein Mcap0476 (RlmFO) catalyzes m5U1939 modification in Mycoplasma capricolum 23S rRNA. Nucleic Acids Res. 2014, 42, 8073–8082. [Google Scholar] [CrossRef]
- Urbonavicius, J.; Brochier-Armanet, C.; Skouloubris, S.; Myllykallio, H.; Grosjean, H. In vitro detection of the enzymatic activity of folate-dependent tRNA (Uracil-54,-C5)-methyltransferase: Evolutionary implications. Methods Enzymol. 2007, 425, 103–119. [Google Scholar] [CrossRef]
- Hamdane, D.; Argentini, M.; Cornu, D.; Golinelli-Pimpaneau, B.; Fontecave, M. FAD/folate-dependent tRNA methyltransferase: Flavin as a new methyl-transfer agent. J. Am. Chem. Soc. 2012, 134, 19739–19745. [Google Scholar] [CrossRef]
- Hamdane, D.; Bruch, E.; Un, S.; Field, M.; Fontecave, M. Activation of a unique flavin-dependent tRNA-methylating agent. Biochemistry 2013, 52, 8949–8956. [Google Scholar] [CrossRef]
- Hamdane, D.; Argentini, M.; Cornu, D.; Myllykallio, H.; Skouloubris, S.; Hui-Bon-Hoa, G.; Golinelli-Pimpaneau, B. Insights into folate/FAD-dependent tRNA methyltransferase mechanism: Role of two highly conserved cysteines in catalysis. J. Biol. Chem. 2011, 286, 36268–36280. [Google Scholar] [CrossRef] [PubMed]
- Kamminga, T.; Koehorst, J.J.; Vermeij, P.; Slagman, S.J.; Martins Dos Santos, V.A.; Bijlsma, J.J.; Schaap, P.J. Persistence of functional protein domains in Mycoplasma species and their role in host specificity and synthetic minimal life. Front. Cell. Infect. Microbiol. 2017, 7, 31. [Google Scholar] [CrossRef] [PubMed]
- Hutchison, C.A., 3rd; Chuang, R.Y.; Noskov, V.N.; Assad-Garcia, N.; Deerinck, T.J.; Ellisman, M.H.; Gill, J.; Kannan, K.; Karas, B.J.; Ma, L.; et al. Design and synthesis of a minimal bacterial genome. Science 2016, 351, aad6253. [Google Scholar] [CrossRef]
- Chen, L.L.; Chung, W.C.; Lin, C.P.; Kuo, C.H. Comparative analysis of gene content evolution in phytoplasmas and mycoplasmas. PLoS ONE 2012, 7, e34407. [Google Scholar] [CrossRef]
- Barre, A.; de Daruvar, A.; Blanchard, A. MolliGen, a database dedicated to the comparative genomics of Mollicutes. Nucleic Acids Res. 2004, 32, D307–D310. [Google Scholar] [CrossRef][Green Version]
- Uchiyama, I.; Mihara, M.; Nishide, H.; Chiba, H. MBGD update 2015: Microbial genome database for flexible ortholog analysis utilizing a diverse set of genomic data. Nucleic Acids Res. 2015, 43, D270–D276. [Google Scholar] [CrossRef] [PubMed]
- Grosjean, H.; Breton, M.; Sirand-Pugnet, P.; Tardy, F.; Thiaucourt, F.; Citti, C.; Barre, A.; Yoshizawa, S.; Fourmy, D.; de Crecy-Lagard, V.; et al. Predicting the minimal translation apparatus: Lessons from the reductive evolution of mollicutes. PLoS Genet. 2014, 10, e1004363. [Google Scholar] [CrossRef]
- Castresana, J. Selection of conserved blocks from multiple alignments for their use in phylogenetic analysis. Mol. Biol. Evol. 2000, 17, 540–552. [Google Scholar] [CrossRef]
- Dereeper, A.; Guignon, V.; Blanc, G.; Audic, S.; Buffet, S.; Chevenet, F.; Dufayard, J.F.; Guindon, S.; Lefort, V.; Lescot, M.; et al. Phylogeny.fr: Robust phylogenetic analysis for the non-specialist. Nucleic Acids Res. 2008, 36, W465–W469. [Google Scholar] [CrossRef]
- Waterhouse, A.M.; Procter, J.B.; Martin, D.M.; Clamp, M.; Barton, G.J. Jalview Version 2—A multiple sequence alignment editor and analysis workbench. Bioinformatics 2009, 25, 1189–1191. [Google Scholar] [CrossRef]
- Bienert, S.; Waterhouse, A.; de Beer, T.A.; Tauriello, G.; Studer, G.; Bordoli, L.; Schwede, T. The SWISS-MODEL Repository-new features and functionality. Nucleic Acids Res. 2017, 45, D313–D319. [Google Scholar] [CrossRef]
- Baker, N.A.; Sept, D.; Joseph, S.; Holst, M.J.; McCammon, J.A. Electrostatics of nanosystems: Application to microtubules and the ribosome. Proc. Natl. Acad. Sci. USA 2001, 98, 10037–10041. [Google Scholar] [CrossRef] [PubMed]
- Giessing, A.M.; Jensen, S.S.; Rasmussen, A.; Hansen, L.H.; Gondela, A.; Long, K.; Vester, B.; Kirpekar, F. Identification of 8-methyladenosine as the modification catalyzed by the radical SAM methyltransferase Cfr that confers antibiotic resistance in bacteria. RNA 2009, 15, 327–336. [Google Scholar] [CrossRef] [PubMed]
- Andersen, T.E.; Porse, B.T.; Kirpekar, F. A novel partial modification at C2501 in Escherichia coli 23S ribosomal RNA. RNA 2004, 10, 907–913. [Google Scholar] [CrossRef] [PubMed][Green Version]
- Douthwaite, S.; Kirpekar, F. Identifying modifications in RNA by MALDI mass spectrometry. Methods Enzymol. 2007, 425, 3–20. [Google Scholar] [CrossRef]
- Kirpekar, F.; Douthwaite, S.; Roepstorff, P. Mapping posttranscriptional modifications in 5S ribosomal RNA by MALDI mass spectrometry. RNA 2000, 6, 296–306. [Google Scholar] [CrossRef] [PubMed]
- Shoji, T.; Takaya, A.; Sato, Y.; Kimura, S.; Suzuki, T.; Yamamoto, T. RlmCD-mediated U747 methylation promotes efficient G748 methylation by methyltransferase RlmAII in 23S rRNA in Streptococcus pneumoniae; interplay between two rRNA methylations responsible for telithromycin susceptibility. Nucleic Acids Res. 2015, 43, 8964–8972. [Google Scholar] [CrossRef][Green Version]
- Ero, R.; Peil, L.; Liiv, A.; Remme, J. Identification of pseudouridine methyltransferase in Escherichia coli. RNA 2008, 14, 2223–2233. [Google Scholar] [CrossRef]
- Purta, E.; Kaminska, K.H.; Kasprzak, J.M.; Bujnicki, J.M.; Douthwaite, S. YbeA is the m3Psi methyltransferase RlmH that targets nucleotide 1915 in 23S rRNA. RNA 2008, 14, 2234–2244. [Google Scholar] [CrossRef]
- Ali, I.K.; Lancaster, L.; Feinberg, J.; Joseph, S.; Noller, H.F. Deletion of a conserved, central ribosomal intersubunit RNA bridge. Mol. Cell 2006, 23, 865–874. [Google Scholar] [CrossRef]
- Ero, R.; Leppik, M.; Liiv, A.; Remme, J. Specificity and kinetics of 23S rRNA modification enzymes RlmH and RluD. RNA 2010, 16, 2075–2084. [Google Scholar] [CrossRef] [PubMed]
- Liu, Q.; Fredrick, K. Intersubunit bridges of the bacterial ribosome. J. Mol. Biol. 2016, 428, 2146–2164. [Google Scholar] [CrossRef] [PubMed]
- Purta, E.; O’Connor, M.; Bujnicki, J.M.; Douthwaite, S. YgdE is the 2′-O-ribose methyltransferase RlmM specific for nucleotide C2498 in bacterial 23S rRNA. Mol. Microbiol. 2009, 72, 1147–1158. [Google Scholar] [CrossRef]
- Hamdane, D.; Bou-Nader, C.; Cornu, D.; Hui-Bon-Hoa, G.; Fontecave, M. Flavin-Protein Complexes: Aromatic stacking assisted by a hydrogen bond. Biochemistry 2015, 54, 4354–4364. [Google Scholar] [CrossRef]
- Nag, L.; Sournia, P.; Myllykallio, H.; Liebl, U.; Vos, M.H. Identification of the TyrOH(*+) Radical Cation in the Flavoenzyme TrmFO. J. Am. Chem. Soc. 2017, 139, 11500–11505. [Google Scholar] [CrossRef]
- Dozova, N.; Lacombat, F.; Bou-Nader, C.; Hamdane, D.; Plaza, P. Ultrafast photoinduced flavin dynamics in the unusual active site of the tRNA methyltransferase TrmFO. Phys. Chem. Chem. Phys. PCCP 2019, 21, 8743–8756. [Google Scholar] [CrossRef]
- Josi, C.; Burki, S.; Vidal, S.; Dordet-Frisoni, E.; Citti, C.; Falquet, L.; Pilo, P. Large-scale analysis of the Mycoplasma bovis genome identified non-essential, adhesion- and virulence-related genes. Front. Microbiol. 2019, 10, 2085. [Google Scholar] [CrossRef] [PubMed]
- Thomas, A.; Linden, A.; Mainil, J.; Bischof, D.F.; Frey, J.; Vilei, E.M. Mycoplasma bovis shares insertion sequences with Mycoplasma agalactiae and Mycoplasma mycoides subsp. mycoides SC: Evolutionary and developmental aspects. FEMS Microbiol. Lett. 2005, 245, 249–255. [Google Scholar] [CrossRef]
- Sirand-Pugnet, P.; Lartigue, C.; Marenda, M.; Jacob, D.; Barre, A.; Barbe, V.; Schenowitz, C.; Mangenot, S.; Couloux, A.; Segurens, B.; et al. Being pathogenic, plastic, and sexual while living with a nearly minimal bacterial genome. PLoS Genet. 2007, 3, e75. [Google Scholar] [CrossRef]
- Lo, W.S.; Gasparich, G.E.; Kuo, C.H. Convergent evolution among ruminant-pathogenic Mycoplasma involved extensive gene content changes. Genome Biol. Evol. 2018, 10, 2130–2139. [Google Scholar] [CrossRef]
- Watts, A.G.; Damager, I.; Amaya, M.L.; Buschiazzo, A.; Alzari, P.; Frasch, A.C.; Withers, S.G. Trypanosoma cruzi trans-sialidase operates through a covalent sialyl-enzyme intermediate: Tyrosine is the catalytic nucleophile. J. Am. Chem. Soc. 2003, 125, 7532–7533. [Google Scholar] [CrossRef] [PubMed]
- Amaya, M.F.; Watts, A.G.; Damager, I.; Wehenkel, A.; Nguyen, T.; Buschiazzo, A.; Paris, G.; Frasch, A.C.; Withers, S.G.; Alzari, P.M. Structural insights into the catalytic mechanism of Trypanosoma cruzi trans-sialidase. Structure 2004, 12, 775–784. [Google Scholar] [CrossRef] [PubMed]
- Koliadenko, V.; Wilanowski, T. Additional functions of selected proteins involved in DNA repair. Free Radic. Biol. Med. 2020, 146, 1–15. [Google Scholar] [CrossRef] [PubMed]
- Guo, Y.; Zhu, H.; Wang, J.; Huang, J.; Khan, F.A.; Zhang, J.; Guo, A.; Chen, X. TrmFO, a fibronectin-binding adhesin of Mycoplasma bovis. Int. J. Mol. Sci. 2017, 18, 1732. [Google Scholar] [CrossRef]

| Enzymes | Substrates | Coenzymes | Carbon Donor | Reducing Agent | Uracil Activation |
|---|---|---|---|---|---|
| TrmA RlmCD | tRNA (U54) rRNA (U747/1939) | none | SAM | none | Cysteine (Michael addition) |
| TrmFO RlmFO | tRNA (U54) rRNA (U1939) | FAD | CH2THF | NAD(P)H | Cysteine (Michael addition) |
| ThyA | dUMP | none | CH2THF | THF | Cysteine (Michael addition) |
| ThyX PolB | Dump UMP | FAD | CH2THF | NAD(P)H | Arginines (Polarization) |
© 2020 by the authors. Licensee MDPI, Basel, Switzerland. This article is an open access article distributed under the terms and conditions of the Creative Commons Attribution (CC BY) license (http://creativecommons.org/licenses/by/4.0/).
Share and Cite
Sirand-Pugnet, P.; Brégeon, D.; Béven, L.; Goyenvalle, C.; Blanchard, A.; Rose, S.; Grosjean, H.; Douthwaite, S.; Hamdane, D.; de Crécy-Lagard, V. Reductive Evolution and Diversification of C5-Uracil Methylation in the Nucleic Acids of Mollicutes. Biomolecules 2020, 10, 587. https://doi.org/10.3390/biom10040587
Sirand-Pugnet P, Brégeon D, Béven L, Goyenvalle C, Blanchard A, Rose S, Grosjean H, Douthwaite S, Hamdane D, de Crécy-Lagard V. Reductive Evolution and Diversification of C5-Uracil Methylation in the Nucleic Acids of Mollicutes. Biomolecules. 2020; 10(4):587. https://doi.org/10.3390/biom10040587
Chicago/Turabian StyleSirand-Pugnet, Pascal, Damien Brégeon, Laure Béven, Catherine Goyenvalle, Alain Blanchard, Simon Rose, Henri Grosjean, Stephen Douthwaite, Djemel Hamdane, and Valérie de Crécy-Lagard. 2020. "Reductive Evolution and Diversification of C5-Uracil Methylation in the Nucleic Acids of Mollicutes" Biomolecules 10, no. 4: 587. https://doi.org/10.3390/biom10040587
APA StyleSirand-Pugnet, P., Brégeon, D., Béven, L., Goyenvalle, C., Blanchard, A., Rose, S., Grosjean, H., Douthwaite, S., Hamdane, D., & de Crécy-Lagard, V. (2020). Reductive Evolution and Diversification of C5-Uracil Methylation in the Nucleic Acids of Mollicutes. Biomolecules, 10(4), 587. https://doi.org/10.3390/biom10040587

